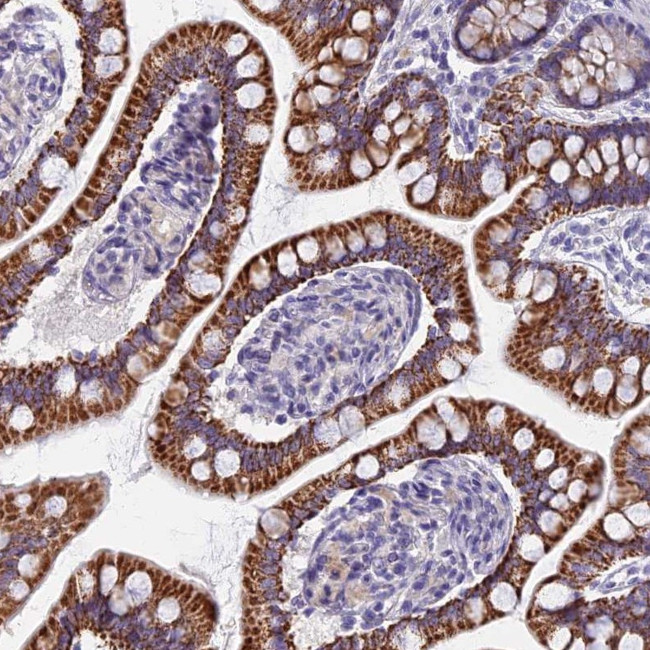
AP4E1 Antibody in Immunohistochemistry (Paraffin) (IHC (P))

Search
Invitrogen
AP4E1 Polyclonal Antibody
{{$productOrderCtrl.translations['antibody.pdp.commerceCard.promotion.promotions']}}
{{$productOrderCtrl.translations['antibody.pdp.commerceCard.promotion.viewpromo']}}
{{$productOrderCtrl.translations['antibody.pdp.commerceCard.promotion.promocode']}}: {{promo.promoCode}} {{promo.promoTitle}} {{promo.promoDescription}}. {{$productOrderCtrl.translations['antibody.pdp.commerceCard.promotion.learnmore']}}
产品信息
PA5-59775
种属反应
宿主/亚型
分类
类型
抗原
偶联物
形式
浓度
规格
纯化类型
保存液
内含物
保存条件
运输条件
RRID
产品详细信息
Immunogen sequence: AELNHNVTYA ILFECVHTVY SIYPKSELLE KAAKCIGKFV LSPKINLKYL GLKALTYVIQ QDPTLALQHQ MTIIECLDHP DPIIKRETLE LLYRITNAQN ITV
Highest antigen sequence identity to the following orthologs: Mouse - 95%, Rat - 95%.
靶标信息
This gene encodes a member of the adaptor complexes large subunit protein family. These proteins are components of the heterotetrameric adaptor protein complexes, which play important roles in the secretory and endocytic pathways by mediating vesicle formation and sorting of integral membrane proteins. The encoded protein is a large subunit of adaptor protein complex-4, which is associated with both clathrin- and nonclathrin-coated vesicles. Disruption of this gene may be associated with cerebral palsy. Alternatively spliced transcript variants encoding multiple isoforms have been observed for this gene.
仅用于科研。不用于诊断过程。未经明确授权不得转售。
篇参考文献 (0)
生物信息学
蛋白别名: adaptor related protein complex 4 epsilon 1 subunit; Adaptor-related protein complex 4 subunit epsilon-1; adaptor-related protein complex AP-4 epsilon; AP-4 adaptor complex subunit epsilon; AP-4 complex subunit epsilon-1; Epsilon subunit of AP-4; Epsilon-adaptin; unnamed protein product
基因别名: AP4E1; CPSQ4; SPG51; STUT1
UniProt ID: (Human) Q9UPM8
Entrez Gene ID: (Human) 23431